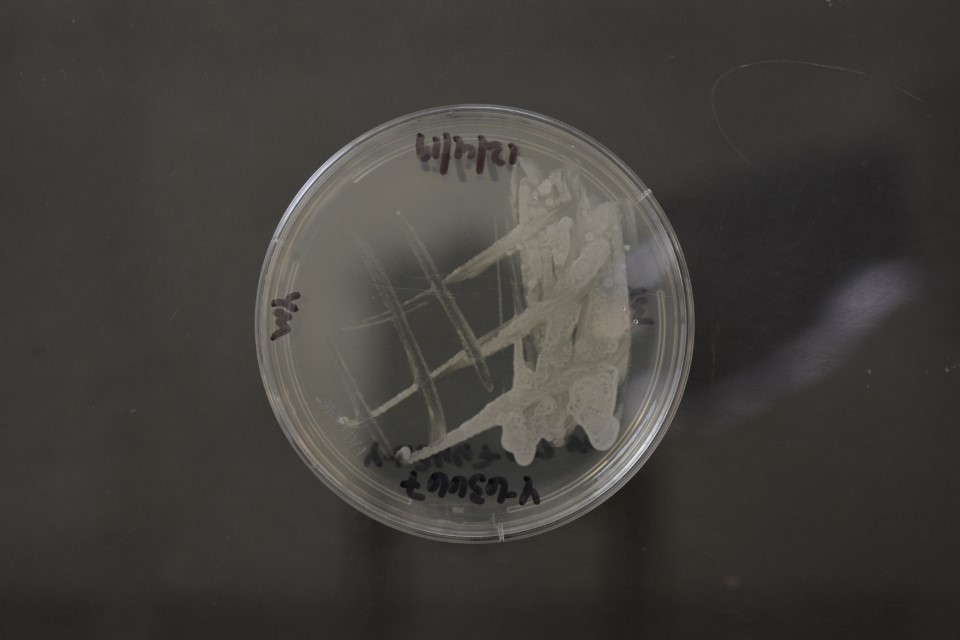

Komagataella kurtzmanii
NRRL Y-63667(Type Strain)
Accession numbers in other collections:CBS 12817=KBP Y-2878=Starmer 75-208.2=UCD 76-20=VKPM Y-727
Source:C.P.Kurtzman-->Gennadi Naumov,State Inst.Genetics Indust.Microorg.
Isolated from(substrate):FX,fir flux
Substrate location:Catalina Mountains,Southern Arizona,USA
Genetic info:GenBank:LSU(KC715720),ITS(KC771256),mito SSU(KC715723),EF-1 alpha(KC715721),RPB1(KC715722).
Growth media:Yeast Extract-Malt Extract-Peptone-Glucose(YM for yeasts)(number 6)
Optimum growth temperature:25C
Strain images:
NRRL_Y-63667_6.JPG

Comments:no growth and 35C and no assimilation of trehalose.MycoBank number MB803919